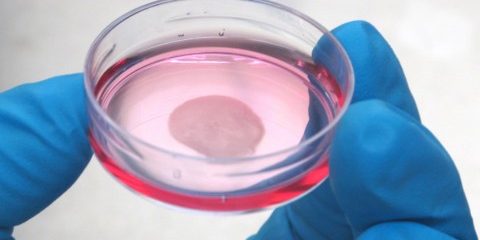

สภาวะเสื่อมของกระดูกอ่อนผิวข้อบริเวณเข่าเป็นหนึ่งในโรคที่พบมากในผู้สูงอายุ ซึ่งเกิดจากการสึกกร่อนตามวัย หรือเกิดความเสียหายอันเนื่องมาจากอุบัติเหตุ แนวทางการรักษาโรคนี้มีตั้งแต่การทำกายภาพบำบัด การใช้ยา ไปจนถึงการผ่าตัดเปลี่ยนผิวข้อเข่าโดยใช้วัสดุไททาเนียมมาทดแทน ในปัจจุบันแพทย์ได้มีการนำเอาเทคโนโลยีด้านวิศวกรรมเนื้อเยื่อมาใช้ในการรักษาข้อเข่าเสื่อมโดยการฉีดเซลล์กระดูกอ่อน (Chondrocytes) ไปยังบริเวณข้อเข่าที่เสียหาย เพื่อกระตุ้นให้เกิดการฟื้นฟูของเนื้อเยื่อกระดูกอ่อนขึ้นมาใหม่ แต่เซลล์กระดูกอ่อนที่ฉีดเข้าไปเป็นเซลล์เดี่ยวๆ ไม่ได้เกาะตรงบริเวณเป้าหมาย จึงเกิดการฟื้นฟูของเนื้อเยื่อใหม่ได้ไม่ดีนัก แต่ด้วยเทคโนโลยีแผ่นเซลล์ (Cell Sheet Technology) ที่สามารถสร้างเซลล์กระดูกอ่อนให้มีลักษณะเป็นแผ่นหลายชั้นได้ จะช่วยให้แพทย์สามารถเคลื่อนย้ายไปแปะลงบนบาดแผลกระดูกอ่อนได้ง่ายและตรงจุดมากยิ่งขึ้น
จากแนวทางการรักษาข้อเข่าเสื่อมแบบใหม่ที่ต้องอาศัยเนื้อเยื้อกระดูกอ่อนที่มีคุณภาพและจับต้องได้โดย ศ.นพ.สารเนตร์ ไวคกุล และ อ.ดร.นพ.โพชฌงค์ โชติญาณวงษ์ แพทย์ผู้เชี่ยวชาญด้านศัลยศาสตร์ออร์โธปิดิกส์และกายภาพบำบัด คณะแพทยศาสตร์ศิริราชพยาบาล มหาวิทยาลัยมหิดล
จึงเป็นจุดเริ่มต้นงานวิจัยของ ดร.โศภิตา วงศ์อินทร์ นักวิจัยหลังปริญญาเอก ศูนย์บริการผลิตเซลล์เชิงพาณิชย์ มหาวิทยาลัยเทคโนโลยีพระจอมเกล้าธนบุรี (มจธ.) ซึ่งในขณะนั้นได้รับทุนวิจัยโครงการปริญญาเอกกาญจนาภิเษก (คปก.) โดยมี รศ.ดร.ขวัญชนก พสุวัต หลักสูตรวิศวกรรมชีวภาพ คณะวิศวกรรมศาสตร์ มจธ. เป็นอาจารย์ที่ปรึกษา ผลิตผลงาน “การสร้างแผ่นเซลล์กระดูกอ่อนหลายชั้นเพื่อรักษาการเสื่อมสภาพของกระดูกอ่อนผิวข้อ” โดยมีเป้าหมายหลักเพื่อให้แพทย์สามารถนำแผ่นเซลล์กระดูกอ่อนนี้ ไปแปะตรงบริเวณกระดูกอ่อนผิวข้อที่เสียหายได้
ดร.โศภิตา กล่าวว่า งานวิจัยนี้ได้นำเซลล์กระดูกอ่อนบริเวณข้อเข่าของผู้ป่วยที่แพทย์วินิจฉัยว่าต้องตัดเข่าทิ้งมาแยกเอาเซลล์กระดูกอ่อน แล้วนำเซลล์เหล่านี้ไปเพิ่มจำนวนในห้องปฏิบัติการให้มากพอ จากนั้นจึงนำไปสร้างเป็นแผ่นเซลล์กระดูกอ่อนด้วยเทคโนโลยีแผ่นเซลล์ ซึ่งเป็นกระบวนการผลิตเนื้อเยื่อแบบใหม่ที่อาศัยการเลี้ยงเซลล์บนภาชนะที่ตอบสนองต่ออุณหภูมิและการปรับเปลี่ยนสภาวะในการบ่มเซลล์ ซึ่งจะช่วยให้สามารถเก็บเซลล์กระดูกอ่อนแบบแผ่นพร้อมโปรตีนที่สำคัญของเซลล์ ทั้งยังสามารถซ้อนแผ่นเซลล์ทับกันหลายชั้นเพื่อเพิ่มความหนาได้ งานวิจัยนี้เราประสบความสำเร็จในการสร้างแผ่นเซลล์กระดูกอ่อน โดยแผ่นเซลล์ที่สร้างได้มีลักษณะผิวเรียบคล้ายกระดูกอ่อนจริง นอกจากนี้เรายังพบว่าในขั้นตอนการเพิ่มจำนวนเซลล์กระดูกอ่อนในห้องปฏิบัติการ และขั้นตอนการสร้างแผ่นเซลล์มีส่วนทำให้รูปร่าง และการผลิตโปรตีนหลักในกระดูกอ่อน (คอลลาเจนชนิดที่ 2) ของเซลล์เปลี่ยนแปลงไป ซึ่งมีผลต่อคุณภาพของแผ่นเซลล์กระดูกอ่อนที่สร้างเป็นอย่างมาก ในขณะนี้ งานวิจัยอยู่ระหว่างการประเมินผลการตอบสนองของกระดูกอ่อนผิวข้อสัตว์ทดลองต่อแผ่นเซลล์กระดูกอ่อนโดยทุนสนับสนุนจากสถาบันวิจัยระบบสาธารณสุข ซึ่งในอนาคตเรามองว่าการสร้างแผ่นเซลล์กระดูกอ่อนหลายชั้นนี้จะช่วยลดปัญหาของการฉีดเซลล์กระดูกอ่อนที่ควบคุมตำแหน่งของเซลล์ได้ยาก และลดปัญหาความเข้ากันได้ทางชีวภาพในวัสดุปลูกฝังไททาเนี่ยม เนื่องจากเป็นเนื้อเยื่อที่สร้างจากเซลล์ของผู้ป่วยเอง
องค์ความรู้จากการสร้างแผ่นเซลล์กระดูกอ่อนนี้สามารถนำไปประยุกต์ใช้กับระบบเลี้ยงเซลล์อัตโนมัติซึ่งเป็นระบบที่สามารถควบคุมสภาวะการเลี้ยงเซลล์กระดูกอ่อนที่ปลอดเชื้อในปริมาณมากได้ ซึ่งจะเป็นประโยชน์อย่างมากต่อการนำไปใช้ในกระบวนการสร้างเป็นผลิตภัณฑ์แผ่นเซลล์ นอกจากนี้กรณีที่ผู้ป่วยบางรายไม่มีกระดูกอ่อนดีเหลืออยู่ การนำเอาเซลล์ต้นกำเนิดชนิดมีเซนไคม์ (mesenchymal stem cells) มาเปลี่ยนเป็นเซลล์กระดูกอ่อนก่อนนำไปสร้างเป็นแผ่นเซลล์แปะกลับไปให้ผู้ป่วยนั้น ยังเป็นอีกหนึ่งองค์ความรู้ที่คณะผู้วิจัยมุ่งพัฒนาเพื่อเป็นอีกหนึ่งทางเลือกให้ผู้ป่วยได้เข้าถึงการรักษามากยิ่งขึ้น